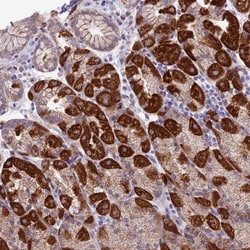
ETFDH Antibody, Novus Biologicals:Antibodies:Primary Antibodies

missing translation for 'onlineSavingsMsg'
Learn More
Learn More
ETFDH Antibody, Novus Biologicals™
Rabbit Polyclonal Antibody
433.00 € - 624.00 €
Specifications
| Antigen | ETFDH |
|---|---|
| Dilution | Western Blot 0.4 ug/ml, Immunohistochemistry 1:50 - 1:200, Immunohistochemistry-Paraffin 1:50 - 1:200 |
| Applications | Western Blot, Immunohistochemistry, Immunohistochemistry (Paraffin) |
| Classification | Polyclonal |
| Conjugate | Unconjugated |
| Produktkod | Brand | Quantity | Pris | Kvantitet och tillgänglighet | |||||
|---|---|---|---|---|---|---|---|---|---|
| Produktkod | Brand | Quantity | Pris | Kvantitet och tillgänglighet | |||||
|
18456030
|
Novus Biologicals
NBP1-83950-25ul |
25 μL |
433.00 €
25µL |
Please sign in to purchase this item. Need a web account? Register with us today! | |||||
|
18292608
|
Novus Biologicals
NBP1-83950 |
0.1 mL |
624.00 €
0.10mL |
Please sign in to purchase this item. Need a web account? Register with us today! | |||||
Beskrivning
ETFDH Polyclonal specifically detects ETFDH in Human samples. It is validated for Western Blot, Immunohistochemistry, Immunohistochemistry-Paraffin.Specifikationer
| ETFDH | |
| Western Blot, Immunohistochemistry, Immunohistochemistry (Paraffin) | |
| Unconjugated | |
| RUO | |
| PBS (pH 7.2) and 40% Glycerol with 0.02% Sodium Azide | |
| 2110 | |
| This antibody was developed against Recombinant Protein corresponding to amino acids:LAVAHEKDIRVCLVEKAAQIGAHTLSGACLDPGAFKELFPDWKEKGAPLNTPVTEDRFGILTEKYRIPVPILPGLPMN | |
| Primary | |
| Store at 4C short term. Aliquot and store at -20C long term. Avoid freeze-thaw cycles. |
| Western Blot 0.4 ug/ml, Immunohistochemistry 1:50 - 1:200, Immunohistochemistry-Paraffin 1:50 - 1:200 | |
| Polyclonal | |
| Rabbit | |
| Human | |
| electron-transferring-flavoprotein dehydrogenaseEC 1.5.5.1, ETFQO, ETF-QO, MADD, mitochondrial | |
| ETFDH | |
| IgG | |
| Affinity Purified | |
| Specificity of antibody verified on a Protein Array containing target protein plus 383 other non-specific proteins. |
For Research Use Only
Hittar du en möjlighet till förbättring?Dela en innehållskorrigering
Korrigering av produktinnehåll
Din input är viktig för oss. Fyll i det här formuläret för att ge feedback relaterad till innehållet på denna produkt.
Produkttitel